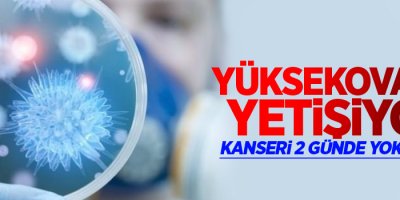
Yüksekova'da yetişiyor, kanseri yok ediyor!

- Elektriksiz ve Susuz Bir Hayat, Yüksekova’da Engelli Çift Yardım Bekliyor
- Doğaya bıraktığı Kızıl Şahin, iki yıl sonra kapısına geri döndü
- Yüksekova Spor, Beşiktaş’ı Tek Golle Yendi
- Hakkari Milletvekili Onur Düşünmez: “Yüksekova Havalimanı 10 Yıldır ILS Bekliyor”
- Yüksekova’da “Milli Birlik ve Beraberlik Buluşması” Programı Düzenlendi
- Hakkari Barosu’ndan DEM Parti Yönetimine Hayırlı Olsun Ziyareti
- Yüksekova’da kar yağışının ardından belediye ekipleri temizlik çalışması başlattı
- Dağlıca Yolunda Heyelan meydana geldi, yol ulaşıma kapandı
- Yüksekova’da etkili olan kar yağışı ilçeyi beyaza bürüdü
- Yüksekova Spor maç öncesi moral yemeğinde buluştu